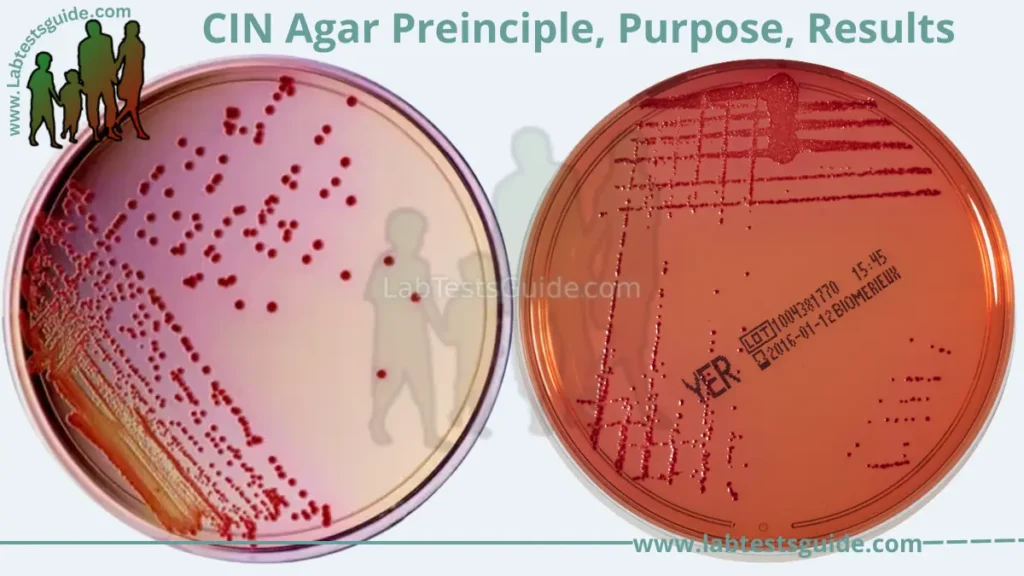
CIN Agar

CIN agar, also known as Cefsulodin-Irgasan-Novobiocin agar, is a selective and differential culture medium used for the isolation and differentiation of Yersinia enterocolitica from other enteric bacteria. The medium contains cefsulodin, irgasan, and novobiocin which inhibit the growth of gram-positive bacteria and many gram-negative bacteria, except for Yersinia enterocolitica. The medium also contains mannitol and phenol red, which serve as indicators of carbohydrate fermentation. Yersinia enterocolitica is able to ferment mannitol, causing a change in the color of the medium from red to yellow. The medium is commonly used in clinical and food microbiology laboratories for the detection and identification of Yersinia enterocolitica in human and animal specimens, as well as in food samples.
Definition of CIN Agar:
CIN agar, also known as Cefsulodin-Irgasan-Novobiocin agar, is a selective and differential culture medium used for the isolation and identification of Yersinia enterocolitica from other enteric bacteria. The medium contains specific antibiotics and indicators that allow for the growth and differentiation of Yersinia enterocolitica.
Purpose and importance of Using CIN Agar:
Here are some purposes and importance of using CIN agar:
- Selective medium: CIN agar is a selective medium that contains specific antibiotics that inhibit the growth of many gram-positive and gram-negative bacteria, except for Yersinia enterocolitica.
- Differential medium: CIN agar contains indicators that allow for the differentiation of Yersinia enterocolitica from other enteric bacteria based on their ability to ferment mannitol.
- Identification of Yersinia enterocolitica: CIN agar is used to isolate and identify Yersinia enterocolitica from clinical and food samples, as it is a common pathogen that can cause diarrhea, fever, and abdominal pain in humans.
- Increased sensitivity: CIN agar is more sensitive than other traditional culture media for the detection of Yersinia enterocolitica.
- Rapid and accurate results: CIN agar allows for the rapid detection and identification of Yersinia enterocolitica, with results typically obtained within 24-48 hours.
- Useful in epidemiological studies: CIN agar can be used in epidemiological studies to investigate outbreaks of Yersinia enterocolitica infections and to determine the source of contamination.
- Cost-effective: CIN agar is a cost-effective method for the detection of Yersinia enterocolitica, compared to other molecular or immunological methods.
- Standardized testing: CIN agar is included in many standard protocols and guidelines for the detection and identification of Yersinia enterocolitica.
Composition and Preparation:
CIN agar contains cefsulodin, irgasan, and novobiocin antibiotics, mannitol, and phenol red indicator in a nutrient agar base. The preparation of CIN agar involves the sterilization of the agar components and their aseptic incorporation at appropriate temperatures, followed by pouring into sterile petri dishes and cooling to solidify.

Ingredients of CIN Agar:
Here are the ingredients typically found in CIN agar:
- Peptone: provides nitrogen and amino acids for bacterial growth
- Yeast extract: provides vitamins and minerals for bacterial growth
- Beef extract: provides nutrients and growth factors for bacteria
- Mannitol: serves as a carbohydrate source and pH indicator
- Phenol red: serves as a pH indicator, with a yellow color indicating acid production
- Cefsulodin: an antibiotic that inhibits gram-negative bacteria
- Irgasan: an antibacterial agent that inhibits gram-positive bacteria and some gram-negative bacteria
- Novobiocin: an antibiotic that inhibits gram-positive bacteria and some gram-negative bacteria
- Agar: a solidifying agent that provides a gel-like consistency to the medium
| Pancreatic Digest of Gelatin | 10.0 Grams |
| Peptic Digest of Animal Tissue | 5.0 Grams |
| Beef Extract | 5.0 Grams |
| Yeast Extract | 2.0 Grams |
| Mannitol | 20.0 Grams |
| Sodium Pyruvate | 2.0 Grams |
| Sodium Chloride | 1.0 Grams |
| Magnesium Sulfate | 0.001 Grams |
| Sodium Desoxycholate | 0.5 Grams |
| Agar | 12.0 Grams |
| Crystal Violet | 0.001 Grams |
| Neutral Red | 0.03 Grams |
| Cefsulodin | 15.0 Grams |
| Irgasan | 4.0 Grams |
| Novobiocin | 2.5 Grams |
Preparation of CIN Agar:
Here is a general procedure for using CIN agar:
- Weigh the above ingredients and dissolve them in 1 liter of distilled or deionized water.
- Adjust the pH of the medium to 7.4 ± 0.2 using 1N sodium hydroxide (NaOH) or 1N hydrochloric acid (HCl).
- Heat the medium with constant stirring until boiling to dissolve the ingredients completely.
- Sterilize the medium by autoclaving at 121°C for 15 minutes.
- Allow the medium to cool to approximately 45-50°C, which is the optimal temperature for pouring into sterile petri dishes.
- Aseptically pour the CIN agar into sterile petri dishes using standard techniques.
- Allow the CIN agar to solidify at room temperature and store the plates in a dry and cool place until use.
Principle and Mechanism of Action:
The principle of using CIN (Cefsulodin-Irgasan-Novobiocin) agar is to selectively isolate Yersinia enterocolitica, a gram-negative bacterium that can cause gastroenteritis in humans. The selective mechanism of CIN agar is based on the incorporation of three antibiotics (cefsulodin, irgasan, and novobiocin) that inhibit the growth of many gram-negative and gram-positive bacteria, but allow the growth of Yersinia enterocolitica.
The mechanism of action of the antibiotics in CIN agar is as follows:
- Cefsulodin: inhibits the growth of most gram-negative bacteria except for Yersinia enterocolitica and some other species, such as Pseudomonas aeruginosa and Proteus mirabilis.
- Irgasan: inhibits the growth of most gram-positive bacteria and some gram-negative bacteria, such as Escherichia coli and Salmonella spp.
- Novobiocin: inhibits the growth of most gram-positive bacteria and some gram-negative bacteria, such as Escherichia coli and Proteus mirabilis.
In addition to the selective mechanism, CIN agar also contains mannitol and phenol red, which serve as a differential mechanism to distinguish Yersinia enterocolitica from other bacteria. Yersinia enterocolitica is capable of fermenting mannitol, which produces acid and turns the phenol red indicator from red to yellow. The yellow color and bull’s eye appearance of the colonies on CIN agar are characteristic of Yersinia enterocolitica.
Overall, the combination of selective and differential mechanisms in CIN agar makes it a useful medium for the isolation and identification of Yersinia enterocolitica from clinical and food samples.
Procedure for using CIN Agar:
Here is a general procedure for using CIN agar:
- Sample collection and preparation: Collect a clinical or food sample suspected of containing Yersinia enterocolitica. Prepare the sample according to standard microbiological techniques, such as dilution, homogenization, or enrichment.
- Inoculation of CIN agar: Aseptically streak or spread a small amount of the prepared sample onto the surface of a CIN agar plate. Label the plate with the sample identification, date, and inoculation technique.
- Incubation conditions: Incubate the CIN agar plate at 25-30°C for 24-48 hours under aerobic conditions.
- Interpretation of results: After incubation, observe the CIN agar plate for growth and morphological characteristics of the colonies. Yersinia enterocolitica colonies typically appear as small, circular, smooth, and grayish-white with a bull’s eye appearance due to mannitol fermentation. Other bacteria may also grow on the CIN agar plate, but they can be differentiated from Yersinia enterocolitica based on their colony morphology and ability to ferment mannitol.
- Further testing: If necessary, further confirm the identity of Yersinia enterocolitica using additional biochemical, serological, or molecular tests.
Note: The specific procedure for using CIN agar may vary depending on the laboratory protocols or specific applications.
Interpretation of Results:
Interpretation of results from CIN agar involves examining the growth and morphological characteristics of the colonies and determining whether they are indicative of Yersinia enterocolitica. Here are some general guidelines for interpreting the results:
- Yersinia enterocolitica: typically appears as small, circular, smooth, and grayish-white colonies with a bull’s eye appearance due to mannitol fermentation. The colonies may also have a pinkish-red halo around them due to the production of siderophores. Further confirmation of the identity of Yersinia enterocolitica may require additional biochemical, serological, or molecular tests.
- Other bacteria: other gram-negative and gram-positive bacteria may also grow on CIN agar but can be differentiated from Yersinia enterocolitica based on their colony morphology and inability to ferment mannitol. For example, E. coli forms pink to red colonies, and Salmonella spp. forms black colonies on CIN agar.
Characteristics of Yersinia enterocolitica on CIN agar:
Yersinia enterocolitica typically appears as small, circular, smooth, and grayish-white colonies on CIN (Cefsulodin-Irgasan-Novobiocin) agar. The colonies may have a bull’s eye appearance due to mannitol fermentation, with a slightly raised center and a transparent zone around the center. The transparent zone results from the diffusion of acids produced by the bacteria during mannitol fermentation. The colonies may also have a pinkish-red halo around them due to the production of siderophores, which are iron-chelating compounds secreted by Yersinia enterocolitica.
The size of the colonies may vary depending on the strain and growth conditions, but typically range from 0.5 to 2.5 mm in diameter. Yersinia enterocolitica colonies on CIN agar are often described as having a characteristic “bull’s eye” appearance, which is a circular colony with a dense center and a translucent zone around it.
Characteristics of other bacteria on CIN agar:
Other bacteria that grow on CIN (Cefsulodin-Irgasan-Novobiocin) agar may have different colony characteristics compared to Yersinia enterocolitica. Here are some examples:
- Escherichia coli: typically forms pink to red colonies with a metallic sheen due to the production of colicins. The colonies are often larger than Yersinia enterocolitica colonies and do not ferment mannitol.
- Salmonella spp.: typically forms black colonies due to the production of hydrogen sulfide. The colonies are often larger than Yersinia enterocolitica colonies and do not ferment mannitol.
- Pseudomonas aeruginosa: may grow on CIN agar due to its intrinsic resistance to cefsulodin. The colonies are typically green and have a fruity odor due to the production of pyocyanin and other pigments.
- Proteus mirabilis: may also grow on CIN agar due to its intrinsic resistance to cefsulodin. The colonies are typically swarming and have a characteristic fishy odor due to the production of urease.
Interpretation of mannitol fermentation and pH indicator:
CIN agar contains mannitol as a carbon source and a pH indicator (phenol red) that changes color depending on the acidity of the medium. The mannitol fermentation and pH indicator can provide information about the metabolic activity of bacteria growing on CIN agar.
Mannitol fermentation is a characteristic of Yersinia enterocolitica, and other mannitol-fermenting bacteria, such as Escherichia coli, can also grow on CIN agar. During mannitol fermentation, the bacteria use the mannitol as a carbon source, and the resulting acid production lowers the pH of the medium. The pH indicator in CIN agar, phenol red, changes color from red to yellow as the pH drops below 6.8, indicating mannitol fermentation. Yersinia enterocolitica produces a characteristic bull’s eye appearance due to the transparent zone around the colonies caused by acid production, which can be used to differentiate it from other mannitol-fermenting bacteria.
Table of Result Interpretation:
Here is a table of colony characteristics of some bacteria on CIN (Cefsulodin-Irgasan-Novobiocin) agar:
| Bacteria | Colony Color | Colony Appearance | Mannitol Fermentation | Other Characteristics |
|---|---|---|---|---|
| Yersinia enterocolitica | Grayish-white | Circular, smooth, “bull’s eye” | Positive | Transparent zone around colonies, pinkish-red halo due to siderophores |
| Escherichia coli | Pink to red | Circular, metallic sheen | Positive | Larger colonies, no mannitol fermentation |
| Salmonella spp. | Black | Circular | Negative | Larger colonies, hydrogen sulfide production |
| Pseudomonas aeruginosa | Green | Circular | Variable | Fruity odor, intrinsic resistance to cefsulodin |
| Proteus mirabilis | Yellow to brown | Swarming | Negative | Fishy odor, intrinsic resistance to cefsulodin |
Note that the colony characteristics may vary depending on the strain and growth conditions of the bacteria. This table is intended to provide a general idea of the differences between some common bacteria that may grow on CIN agar.
Advantages and limitations:
Advantages of using CIN agar:
- Selectivity: CIN agar is a selective medium that inhibits the growth of many Gram-positive and some Gram-negative bacteria, allowing for the isolation and identification of specific Gram-negative bacterial species such as Yersinia enterocolitica.
- Differential properties: CIN agar is a differential medium that allows for the differentiation of bacterial species based on their ability to ferment mannitol and produce acid, as well as other characteristic colony appearances.
- Easy to use: CIN agar is relatively easy to prepare and use, and the results can be easily interpreted.
- Cost-effective: CIN agar is a relatively inexpensive medium, making it an attractive option for routine use in clinical and research settings.
Limitations of using CIN agar:
- False-negative results: Some strains of Yersinia enterocolitica may not grow on CIN agar, leading to false-negative results.
- False-positive results: Other bacteria, such as E. coli, can also grow on CIN agar and produce similar colony appearances, potentially leading to false-positive results.
- Limited specificity: While CIN agar is selective for Gram-negative bacteria, it may not be specific enough to completely eliminate the growth of other Gram-negative bacteria that are not of interest.
- Interpretation challenges: Colony appearances can vary depending on the strain and growth conditions, and some bacterial species may exhibit atypical colony appearances on CIN agar, making interpretation challenging.
- Limited information: While CIN agar provides information about mannitol fermentation and certain colony appearances, it may not provide comprehensive information about the bacterial species of interest. Additional tests may be necessary to confirm identity and characteristics.
Applications and significance:
CIN agar is a useful tool in the identification and isolation of certain Gram-negative bacteria, particularly Yersinia enterocolitica. Some of the applications and significance of CIN agar include:
- Clinical microbiology: CIN agar can be used to identify Yersinia enterocolitica from clinical specimens such as feces, blood, and cerebrospinal fluid. Yersinia enterocolitica is a common cause of gastroenteritis, and early and accurate diagnosis can help guide appropriate treatment and prevent complications.
- Food microbiology: CIN agar can be used to detect and isolate Yersinia enterocolitica from food samples, particularly raw and undercooked pork products that are a common source of infection.
- Research: CIN agar can be used in research settings to study the ecology, pathogenesis, and antimicrobial resistance of Yersinia enterocolitica and other Gram-negative bacteria.
- Public health: CIN agar is an important tool in the surveillance and control of Yersinia enterocolitica outbreaks, particularly in foodborne settings.
- Veterinary medicine: CIN agar can be used to detect and isolate Yersinia enterocolitica from animal specimens, particularly pigs, which are a common reservoir of the bacteria.
10 FAQs:
What is CIN agar used for?
CIN agar is a selective and differential medium used for the isolation and identification of Gram-negative bacteria, particularly Yersinia enterocolitica.
What does CIN stand for in CIN agar?
CIN stands for Cefsulodin-Irgasan-Novobiocin, which are the three antibiotics present in the agar that inhibit the growth of many Gram-positive and some Gram-negative bacteria.
What are the colony characteristics of Yersinia enterocolitica on CIN agar?
Yersinia enterocolitica typically produces small, round, translucent colonies with a red center and a clear outer edge.
What other bacterial species can grow on CIN agar?
Other bacterial species that can grow on CIN agar include Escherichia coli, Klebsiella pneumoniae, and some strains of Proteus spp.
What is the mechanism of action of CIN agar?
Cefsulodin, Irgasan, and Novobiocin in the agar inhibit the growth of many Gram-positive and some Gram-negative bacteria. The presence of mannitol and pH indicator allows for the differentiation of bacterial species based on their ability to ferment mannitol and produce acid.
What are the limitations of using CIN agar?
Some limitations of using CIN agar include false-negative and false-positive results, limited specificity, and interpretation challenges.
Can CIN agar be used to identify other Gram-negative bacteria?
While CIN agar is selective for Gram-negative bacteria, it may not be specific enough to completely eliminate the growth of other Gram-negative bacteria that are not of interest.
How is CIN agar prepared?
CIN agar is prepared by dissolving the agar base in water, adding the antibiotics, mannitol, and pH indicator, and sterilizing by autoclaving.
What is the shelf life of CIN agar?
The shelf life of CIN agar is typically around six months if stored properly at room temperature.
What are some alternative methods for identifying Yersinia enterocolitica?
Other methods for identifying Yersinia enterocolitica include PCR, biochemical tests, and serological methods.
Conclusion:
CIN agar is a selective and differential medium used for the isolation and identification of Gram-negative bacteria, particularly Yersinia enterocolitica. The presence of cefsulodin, irgasan, and novobiocin in the agar inhibits the growth of many Gram-positive and some Gram-negative bacteria. The presence of mannitol and pH indicator allows for the differentiation of bacterial species based on their ability to ferment mannitol and produce acid. CIN agar is widely used in clinical, research, and public health settings for the identification and isolation of Yersinia enterocolitica and other Gram-negative bacteria. While CIN agar has its limitations, it is an important tool in the surveillance and control of Yersinia enterocolitica outbreaks, particularly in foodborne settings.
References:
- Kimura, A. C., & Schuetz, A. N. (2018). Yersinia enterocolitica: microbiology, epidemiology, and pathogenesis. Clinics in laboratory medicine, 38(1), 29-39. https://www.ncbi.nlm.nih.gov/pmc/articles/PMC5778895/
- Kiehlbauch, J. A., Brenner, D. J., Nicholson, M. A., Baker, C. N., Patton, C. M., & Steigerwalt, A. G. (1982). Campylobacter butzleri sp. nov. isolated from humans and animals with diarrheal illness. Journal of clinical microbiology, 16(6), 932-937. https://www.ncbi.nlm.nih.gov/pmc/articles/PMC272258/
- Bauer, A. W., Kirby, W. M. M., Sherris, J. C., & Turck, M. (1966). Antibiotic susceptibility testing by a standardized single disk method. American Journal of Clinical Pathology, 45(4), 493-496. https://academic.oup.com/ajcp/article/45/4_ts/493/1768586
- APHA (American Public Health Association). (2015). Standard Methods for the Examination of Water and Wastewater. APHA.
- Wauters, G., & Kandolo, K. (1987). New enrichment method for isolation of Yersinia enterocolitica serotype O: 3 from pork. Applied and environmental microbiology, 53(4), 791-793. https://www.ncbi.nlm.nih.gov/pmc/articles/PMC203837/







